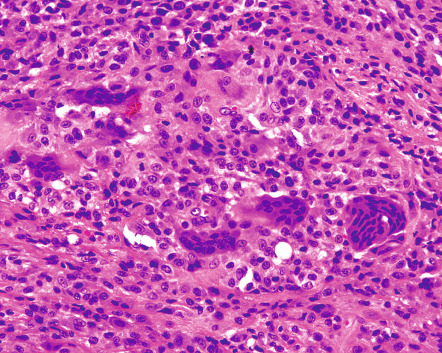

Abstract
Fibrous and fibrohistiocytic proliferations of the skin and tendons comprise a heterogeneous group of both benign and malignant mesenchymal tumors. Predominant tumor cells are CD34 + fibroblasts, α-smooth muscle actin-positive myofibroblasts and factor XIIIa-positive dermal dendritic cells, in conjunction with CD68 + histiocytes and macrophages. Recent advances in immunohistochemistry and molecular pathology (FISH, RT-PCR) allow precise histopathologic classification and diagnosis. Diagnostically relevant translocations and fusion genes can be found in dermatofibrosarcoma protuberans (DFSP) and its morphological variant giant cell fibroblastoma, as well as in nodular fasciitis. Of note, the latter has been reclassified as a “transient neoplasia”. Remarkable is the metastatic potential of a small subgroup of fibrous histiocytomas which so far elude precise clinicopathologic characterization. Epithelioid sarcoma, a perfect clinicopathologic imitator of granulomatous or epithelial proliferations, can be identified immunohistochemically by its distinct loss of the tumor suppressor gene SMARCB1/INI1 .
Keywords
skin tags, acrochordons, cutaneous angiofibroma, dermatofibroma, fibrous histiocytoma, acral fibrokeratoma, superficial acral fibromyxoma, sclerotic fibroma of the skin, pleomorphic fibroma of the skin, epithelioid fibrous histiocytoma, multinucleate cell angiohistiocytoma, dermatomyofibroma, giant cell tumor of tendon sheath, fibroma of tendon sheath, nodular fasciitis, connective tissue nevus, fibroblastic connective tissue nevus, infantile digital fibroma, infantile myofibromatosis, cutaneous adult myofibroma, calcifying aponeurotic fibroma, fibrous hamartoma of infancy, fibromatoses, plexiform fibrohistiocytic tumor, atypical fibroxanthoma, AFX, dermatofibrosarcoma protuberans, DFSP, giant cell fibroblastoma, fibrosarcoma, epithelioid sarcoma, pleomorphic dermal sarcoma, COL1A1-PDGFB fusion gene, SMARCB1/INI1
- ▪
Fibrous and fibrohistiocytic proliferations of the skin and tendons are common lesions that include both neoplastic and “reactive” processes
- ▪
Common benign fibrous and fibrohistiocytic proliferations, some of their atypical variants that could be misdiagnosed as malignant tumors, and corresponding malignant neoplasms are reviewed
- ▪
These tumors are composed of fibroblasts, myofibroblasts, histiocytes, dermal dendritic cells, collagen fibers, elastic fibers and connective tissue mucin, each present in variable proportions depending upon the particular lesion
- ▪
Immunohistochemical stains are helpful in identifying CD34 + fibroblasts, α-smooth muscle actin-positive myofibroblasts and factor XIIIa-positive dermal dendritic cells, as well as CD68-positive histiocytes and macrophages
- ▪
For some tumors (e.g. DFSP, nodular fasciitis), RT-PCR and fluorescent in situ hybridization (FISH) can detect distinct translocations and fusion genes, allowing for more precise diagnoses
Skin Tags
▪ Acrochordons ▪ Fibroepithelial polyps ▪ Soft fibromas
Clinical Features
Skin tags are very common, presenting as soft, skin-colored to slightly hyperpigmented, pedunculated papules that favor the neck, axilla and groin ( Fig. 116.1 ). Skin tags are usually asymptomatic, but can become painful secondary to irritation or infarction.

Epidemiology
Men and women are equally affected, and close to 50% of all individuals have at least one skin tag . Although skin tags were once thought to be associated with colonic polyps, more recent studies have not confirmed this relationship . Skin tags have also been reported as a cutaneous marker for diabetes mellitus .
Pathology
Histologically, skin tags are polypoid with loose to dense collagenous stroma and thin-walled blood vessels.
In Birt–Hogg–Dubé syndrome and Cowden syndrome, patients can have typical skin tags, but sometimes the “skin tags” represent fibrofolliculomas, trichodiscomas or perifollicular fibromas, versus sclerotic fibromas, respectively .
Treatment
Unless irritated or infarcted, skin tags are more of a cosmetic issue than a clinical concern and can be removed by scissor excision.
Cutaneous Angiofibroma
▪ Fibrous papule ▪ Pearly penile papule ▪ Ungual fibroma ▪ Fibrous papule of the nose
Clinical Features
Fibrous papules are solitary, dome-shaped and shiny, skin-colored to reddish papules located on the face of adults, most commonly on the nose ( Fig. 116.2 ) . Clinically, they can mimic small intradermal melanocytic nevi, basal cell carcinomas (BCCs), or adnexal tumors. By dermoscopy, a white color is often seen.

Pearly penile papules are pearly, white, dome-shaped, closely aggregated small papules located on the glans penis, commonly in a multilayered and circumferential manner on the corona ( Fig. 116.3 ). They are found in up to 30% of young postpubertal adults, and are more common in uncircumcised men . They can be mistaken for condylomata acuminata or hypertrophied sebaceous glands.

Multiple facial angiofibromas are seen in tuberous sclerosis (TS), multiple endocrine neoplasia type 1, Birt–Hogg–Dubé syndrome , and rarely, neurofibromatosis type 2. They are usually distributed bilaterally on the cheeks, nasolabial folds, nose and chin. In TS, facial angiofibromas usually appear during early to mid childhood. Patients with TS can also have multiple ungual angiofibromas . Both facial (≥3) and ungual (≥2) angiofibromas represent major diagnostic criteria for TS (see Table 61.8 ).
Pathology
All angiofibromas are dome-shaped lesions composed of a dermal proliferation of plump or stellate fibroblasts in a collagenous stroma with an increase in the number of thin-walled, dilated blood vessels ( Fig. 116.4 ). The collagen fibers can be arranged in a concentric fashion around hair follicles and blood vessels (a variant known as perifollicular fibroma). Elastic fibers are decreased in number. Some fibroblasts can be multinucleated. Granular and clear-cell variants have been described.

Dermatofibroma
▪ Fibrous histiocytoma ▪ Benign fibrous histiocytoma ▪ Fibroma simplex ▪ Sclerosing hemangioma ▪ Nodular subepidermal fibrosis ▪ Histiocytoma ▪ Dermal dendrocytoma
Clinical Features
Dermatofibromas are seen primarily in adults and favor the lower extremities. They are firm, minimally elevated to dome-shaped papules that usually measure from a few millimeters to 1 cm in diameter, but occasionally are up to 2 cm in size. The lesions are commonly hyperpigmented ( Fig. 116.5 ). On palpation, they may seem attached to the subcutaneous tissue; pinching the lesion gently usually results in apparent downward movement of the tumor, also known as the “dimple sign”. By dermoscopy, a central white scar-like patch or white network surrounded by a delicate pigment network is most commonly observed (see Ch. 0 ).

Although some dermatofibromas are thought to arise at sites of trauma or arthropod bites, their precise etiology is not known. Multiple eruptive dermatofibromas have been observed in patients with autoimmune disorders (e.g. lupus erythematosus) and atopic dermatitis and in the setting of immunosuppression (e.g. HIV infection) . Clinically, dermatofibromas can be confused with cysts or melanocytic nevi, especially those with fibrosis. In the case of larger lesions, the possibility of dermatofibrosarcoma protuberans (DFSP), which is less well defined and multilobed, may be considered.
Pathology
Dermatofibromas are characterized by a nodular dermal proliferation, predominantly of spindle-shaped fibroblasts and myofibroblasts arranged as short intersecting fascicles ( Fig. 116.6 ). The fibroblasts and myofibroblasts have plump oval nuclei with small nucleoli; mitoses may be present. There may be a component of mono- or multinucleated histiocytes with vacuolated (xanthomatous) cytoplasm (hence the synonym benign fibrous histiocytoma). “Keloidal” collagen bundles, which are refractile with polarized light, are seen at the periphery ( Fig. 116.7 ); the presence of peripheral “entrapped” collagen bundles is considered a classic hallmark of dermatofibroma. Hemorrhage into a dermatofibroma (sclerosing hemangioma) explains the common finding of hemosiderin.


The overlying epidermis is usually hyperplastic. Sometimes there are aggregates of basaloid cells with follicular differentiation emanating from the epidermis (follicular and basaloid “induction”), which may be confused with a superficial BCC. There are, however, a few reported cases of true BCCs evolving within longstanding dermatofibromas . Histologic variants of dermatofibroma are listed in Table 116.1 .
| CLINICAL AND HISTOPATHOLOGIC VARIANTS OF DERMATOFIBROMA/FIBROUS HISTIOCYTOMA |
| Clinical variants |
|
| Histopathologic variants |
|
Positive immunohistochemical reactions for vimentin, factor XIIIa , stromelysin-3 , muscle-specific actin and CD68, as well as a negative reaction for CD34, support a diagnosis of dermatofibroma. Evolving cellular dermatofibromas may stain strongly for α-smooth muscle actin. The histologic differential diagnosis includes keloid, scar, connective tissue nevus, dermatomyofibroma, DFSP (CD34-positive), and nodular Kaposi sarcoma. Of note, dermatofibromas may show CD34 positivity at the periphery while the center is usually CD34-negative, in contrast to DFSP which is homogeneously CD34-positive.
Whether dermatofibromas are reactive or neoplastic has been an area of controversy for a long time. The recent detection of clonality in a subset of fibrous histiocytomas in addition to a large size, mitotic activity and/or high recurrence rate in some dermatofibromas and the very rare metastatic potential suggest that fibrous histiocytoma is a tumor rather than a reactive inflammatory process .
Treatment
Dermatofibromas may be biopsied or excised to exclude a melanocytic proliferation, a fibrosed cyst or other mesenchymal neoplasm. Undisturbed, dermatofibromas usually persist, but with time may undergo partial regression, especially centrally.
Variants of Dermatofibroma
The many clinical and histologic variants of dermatofibroma are listed in Table 116.1 and key features of selected variants are outlined in Table 116.2 .
| HISTOLOGIC VARIANTS OF DERMATOFIBROMA/FIBROUS HISTIOCYTOMA | |||
|---|---|---|---|
| Variant | Clinical features | Histopathologic features | DDx/Comments |
| Epithelioid fibrous histiocytoma (epithelioid cell histiocytoma) | Firm, sessile or polypoid papules or nodules 0.5–1.5 cm in diameter | Dome-shaped or polypoid dermal nodules with peripheral adnexal collarettes Monomorphous population of large, stellate and triangular, epithelioid cells with eosinophilic cytoplasm & oval nuclei with small nucleoli; some cells have 2 or more nuclei; no nesting of cells Rare mitotic figures Cells separated by delicate collagen fibers & variable amounts of mucin Proliferation of small blood vessels can be seen | When vascular in appearance, pyogenic granuloma or sclerosing hemangioma ALK rearrangement and overexpression |
| Lipidized fibrous histiocytoma (“ankle-type” fibrous histiocytoma) | Striking predilection for the lower extremity, in particular the ankle | Large foam cells and interspersed siderophages predominate Focally, features of an ordinary fibrous histiocytoma (e.g. peripheral “entrapped” dermal collagen) can be seen | Prognosis excellent |
| Fibrous histiocytoma of the face | Dermal/subcutaneous plaque | Predominance of distinct cellular fascicles & bundles of spindle-shaped tumor cells plus classic features of a fibrous histiocytoma Often extend into the subcutaneous fat and deeper soft tissues, including striated muscle | Compared to classic fibrous histiocytomas located elsewhere, excised with wider margins because of diffuse infiltration, involvement of deeper tissues, and increased rate of local recurrences |
| Deep dermatofibroma (extending into subcutaneous tissue) | Usually on the trunk and proximal extremities 1–2 cm in diameter | Similar features to common DF, but extension of dermal components into subcutis Extension via two patterns:
| Clinically, may resemble lipoma or DFSP Histologically, absence of the multilayered & “honeycomb” patterns characteristic of DFSP |
| Aneurysmal fibrous histiocytoma (hemorrhagic or hemosiderotic dermatofibroma) | Large size and nodular or dome-shaped with a history of recent rapid growth | Large blood-filled spaces rimmed by densely aggregated siderophages but without the typical endothelial lining of vascular structures (pseudovascular spaces; hemorrhagic pseudocysts; Fig. 116.8 ) Extravasation of erythrocytes Sheets of large histiocytes & brown, Prussian blue-positive siderophages interspersed with small capillaries without endothelial atypia Siderophages may be multi-nucleated Also conventional features of histiocyte-rich fibrous histiocytoma | Clinically and histologically may be confused with malignant vascular tumors or angiomatoid fibrous histiocytoma IHC staining with the endothelial marker CD31 may lead to confusion as also stains phagocytic histiocytes and siderophages |
| Dermatofibroma with atypical cells (with “monster” cells or pseudosarcomatous dermatofibroma) | Middle-aged adults Slightly >1 cm in diameter | Architectural pattern & components of a common DF plus atypical mono- and multinucleated cells with large pleomorphic and hyperchromatic nuclei, some of which have prominent nucleoli ( Fig. 116.9 ) Cells have abundant vacuolated cytoplasm, often with hemosiderin deposits Rare mitotic figures and no atypical mitoses | Current recommendation is to treat with clinical caution If in addition to features of a DF with atypical cells, there are numerous mitoses and many of the mitoses are atypical, then the tumor should be labeled a low-grade superficial cutaneous sarcoma or atypical fibrohistiocytic tumor with a genuine, but exceeding low, metastatic potential |
| Metastasizing fibrous histiocytoma | Metastases are well-documented but exceedingly rare | To date, no specific histologic feature predicts metastatic behavior Warning signs – large primary tumor, extension into subcutis with infiltrative peripheral borders, high proliferation rate (Ki67) & mitotic activity, & multiple recurrences Includes aneurysmal, cellular, and atypical fibrous histiocytomas | Cytogenetic aberrations detected via aCGH may reflect a biologic continuum with 0 in common fibrous histiocytomas to some in atypical fibrous histiocytomas to many in malignant fibrous histocytomas/sarcomas In metastasizing fibrous histiocytomas, genetic aberrations were seen in 2 to 3 chromosomes |


Acral Fibrokeratoma
▪ Acquired digital fibrokeratoma
Clinical Features
These uncommon lesions present as a solitary, skin-colored to pink, slightly keratotic, exophytic papulonodule with a collarette of elevated skin ( Fig. 116.10 ). Acquired fibrokeratomas usually occur in middle-aged adults and the most common site is the finger . Clinically, they can resemble a supernumerary digit (see Ch. 64 ), ungual fibroma, or verruca.

Pathology
Acral fibrokeratomas are composed of thick collagen bundles surrounded by blood vessels, oriented perpendicularly to the epidermis ( Fig. 116.10 , inset) . The histopathologic differential diagnosis includes ungual fibroma and supernumerary digit .
Superficial Acral Fibromyxoma
▪ Acral fibromyxoma ▪ Digital fibromyxoma ▪ Cellular digital fibroma
Clinical Features
Superficial acral fibromyxoma is a rare tumor of acral sites first described in 2001 . There is a 2 : 1 male : female ratio, with a broad range for age of onset . The tumor presents as a slowly enlarging, often painful mass, attaining an average size of 2 cm. It usually develops on the toes or fingers, with two-thirds of tumors occurring close to or involving the nail bed ; 3% of tumors invade adjacent bone . Less common sites include the palm or heel . The clinical differential diagnosis includes ungual fibroma, verruca, and giant cell tumor of the tendon sheath.
Pathology
Superficial acral fibromyxomas are located within the dermis with extension into the subcutis. There are non-encapsulated, poorly marginated masses composed of spindled to stellate cells arranged in a vague storiform or loosely fascicular growth pattern ( Fig. 116.11 ). The stroma is myxoid to fibromyxoid with prominent blood vessels and frequent mast cells. Most tumors have alternating areas of fibrous and myxoid stroma . Minimal cellular atypia is common, and occasionally scattered larger cells with so-called “degenerative change” are present . Mitotic figures are rare. Significant pleomorphism, neural/perineural infiltration, and necrosis are not seen. In cases involving the nail bed, there is often papillary hyperplasia of the nail bed epithelium .

The majority of these tumors stain strongly for CD34 and frequently for CD99 and CD10 , with focal expression of epithelial membrane antigen, nestin, desmin, and α-smooth muscle actin . The histologic differential diagnosis includes cellular fibroma, myxoid neurofibroma, superficial angiomyxoma, and DFSP.
Treatment
These tumors follow a benign course, with the minority (~25%) recurring after complete excision . Neither malignant transformation nor metastasis has been reported .
Sclerotic Fibroma of the Skin
Clinical Features
This distinct, very collagenous variant of fibroma was originally reported as a component of Cowden syndrome (PTEN hamartoma tumor syndrome). However, a sporadic solitary form has also been described .
In Cowden syndrome, the sclerotic fibromas can be solitary or multiple. They appear on the skin and/or mucous membranes as pearly papules or nodules that measure from a few to up to 10 mm in diameter.
Pathology
Sclerotic fibromas are well-circumscribed, dome-shaped, dermal hypocellular nodules composed predominantly of sclerotic thick collagen bundles. The bundles are arranged as short intersecting stacks in a parallel arrangement and are separated by spaces containing connective tissue mucin (plywood-like or whorl-like pattern; Fig. 116.12 ). Between the collagen bundles, there are thin spindled cells. The spindle cells react positively for vimentin, muscle-specific actin, and CD34 . Positivity for CD34 may result in the misdiagnosis of early DFSP.

Pleomorphic Fibroma of the Skin
Clinical Features
This unusual variant of a fibroma was described by Kamino et al. in 1989. Pleomorphic fibromas of the skin usually present in adults, with a slight preponderance in women. They favor the extremities and appear as asymptomatic, solitary, skin-colored, dome-shaped or polypoid papules which measure from a few millimeters to nearly 2 cm in diameter. Clinically, they resemble skin tags, neurofibromas, or intradermal melanocytic nevi. Treatment is simple excision, and to date there have been no reports of recurrence.
Pathology
Pleomorphic fibromas are polypoid or dome-shaped, well-circumscribed dermal lesions characterized by low cellularity with a predominance of thick collagen bundles in a haphazard array. There are scattered spindled cells and irregularly shaped multinucleated cells with scanty cytoplasm, indistinct cellular borders, and large pleomorphic and hyperchromatic nuclei ( Fig. 116.13 ). Some of the multinucleated cells have multilobed nuclei. Mitotic figures are rare.

The spindle-shaped cells and the irregularly shaped, multinucleated cells are positive for vimentin and CD34 , and the spindle-shaped cells react positively for muscle-specific actin. The differential diagnosis includes dermatofibroma with atypical cells, atypical fibroxanthoma, and neurofibroma with atypical cells. Superficial variants of pleomorphic lipoma or cutaneous atypical lipomatous tumor (ALT) have similar histologic features as pleomorphic fibroma albeit with larger numbers of entrapped adipocytes as well as occasional lipoblasts in ALT.
Multinucleate Cell Angiohistiocytoma
Clinical Features
The typical clinical presentation of multinucleate cell angiohistiocytomas is that of slowly growing, multiple, discrete but grouped, red to violaceous papules, usually on the lower extremities or the dorsal aspect of the hands ( Fig. 116.14 ). The lesions may be unilateral or bilateral, and typically affect women over 40 years of age . A generalized form has also been described . Clinically, lesions may resemble Kaposi sarcoma, granuloma annulare, or sarcoidosis.

Pathology
These lesions are composed of a proliferation of dilated capillaries and small venules in the superficial to mid dermis within thickened collagen bundles ( Fig. 116.15 ). The characteristic cell is a multinucleated giant cell, sometimes with peripheral palisading of the nuclei within eosinophilic cytoplasm ( Fig. 116.15 , inset). The histopathologic differential diagnosis includes dermatofibroma, angiofibroma, hemangioma, and interstitial granuloma annulare.

Treatment
These lesions are benign. If left untreated, most cases progress slowly without evidence of spontaneous resolution.
Dermatomyofibroma
This tumor was described as plaque-like dermal fibromatosis in 1991 by Hügel and as dermatomyofibroma by Kamino et al. . It is a benign fibroblastic/myofibroblastic dermal neoplasm .
Clinical Features
Dermatomyofibromas most commonly occur in young women and favor the shoulder area, axilla, upper arm, and neck. Occasionally, these tumors arise during childhood. They are asymptomatic, well-circumscribed, oval or annular, skin-colored to red–brown plaques that have a smooth surface and measure 1–2 cm in diameter.
Pathology
Dermatomyofibromas are well-circumscribed plaques involving the reticular dermis and the upper portion of the subcutaneous septae; they are composed of well-defined, long fascicles of spindle-shaped cells parallel to the skin surface ( Fig. 116.16 ). The cells have a very uniform appearance, with elongated nuclei having rounded or pointed ends and one or two small nucleoli. There is no evidence of nuclear atypia, and mitoses are rare. The cells are separated by thin collagen fibers and elastic fibers are preserved. The fascicles, spindle-shaped cells, collagen fibers and elastic fibers may have a wavy appearance. The adnexal structures are spared.

With Verhoeff–van Gieson stain, the elastic fibers appear slightly increased in number. The spindle-shaped cells react positively for vimentin and are variably positive for muscle-specific actin; staining for desmin, factor XIIIa, and CD34 is negative. These results support a fibroblastic/myofibroblastic differentiation rather than smooth muscle differentiation . On electron microscopy, the myofibroblasts contain prominent rough endoplasmic reticulum and intracytoplasmic myofilaments . The histologic differential diagnosis includes dermatofibroma and fibroblastic connective tissue nevus.
Treatment
The treatment is simple excision. Recurrence is uncommon even when marginally or incompletely excised .
Giant Cell Tumor of Tendon Sheath
▪ Tenosynovial giant cell tumor (localized type) ▪ Localized nodular tenosynovitis ▪ Giant cell synovioma
Clinical Features
This tumor usually presents as a firm nodule on the hand or finger ( Fig. 116.17 ), but can also occur on the toes and other periarticular sites. It is typically slow growing and fixed to subcutaneous structures without attachment to the overlying skin, except on the distal fingers and toes. Although usually asymptomatic, there can be pain, numbness or stiffness of the affected digit.

Giant cell tumor of tendon sheath is the most common tumor of the hand and can present at any age, but usually appears in adults 30 to 50 years of age and is more common in women than in men .
Pathology
These tumors have a lobular outline and are attached to the tendon sheath. They have a biphasic appearance, with moderately cellular areas of rounded to polygonal cells blending into hypocellular collagenized areas with spindle cells. The characteristic multinucleated giant cells are scattered throughout the tumor in variable densities. These cells have eosinophilic cytoplasm and from a few to 50 nuclei ( Fig. 116.18 ). There are also both large and small mononucleated histiocytes with abundant vacuolated cytoplasm containing variable amounts of hemosiderin deposits. Stromal clefts, mitotic figures, and, rarely, vascular involvement may be observed.
By immunohistochemistry, the larger mononuclear cells express clusterin and occasionally desmin while the smaller histiocyte-like cells are positive for CD68, CD163, and CD45. Remarkably, there is always a focal leukocyte common antigen (LCA)-positive lymphocytic infiltrate. Cytogenetically, this tumor has characteristic translocations, in particular t(1;2)(p13;q37) which fuses two genes – CSF1 at 1p13 encoding colony-stimulating factor-1 and COL6A3 at 2q37 encoding collagen type VI α-3 . This fusion leads to an overexpression of CSF1, which attracts large numbers of macrophages to the tumor site. The histologic differential diagnosis includes epithelioid sarcoma, synovial sarcoma, and deep dermatofibroma.
Treatment
This tumor is benign, with a local recurrence rate of 30%. It can be treated by simple excision .
Stay updated, free articles. Join our Telegram channel
Full access? Get Clinical Tree





